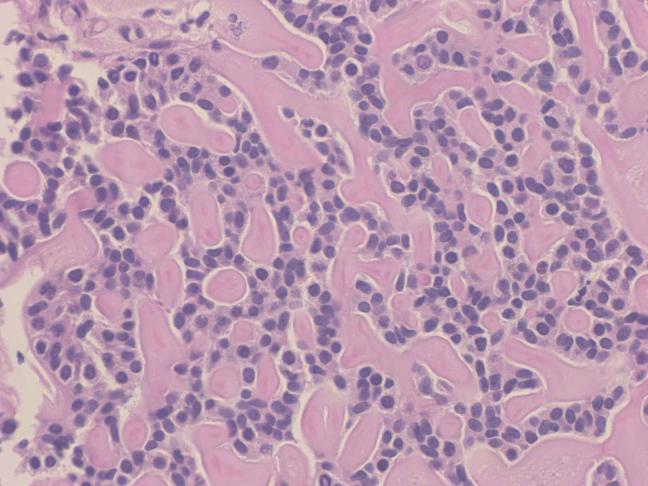
https://cdn.ncbi.nlm.nih.gov/pmc/blobs/4439/4714274/7b989560ba37/gr2.jpg

部分睾丸切除术治疗良性硬化性支持细胞瘤:1例与睾丸微石症相关的罕见肿瘤报告
Partial Orchiectomy for the Treatment of a Benign Sclerosing Sertoli Cell Tumor: A Report of a Rare Tumor in Association With Testicular Microlithiasis.
作者信息
Ball Adam James
机构信息
Gulfstream Urology Associates, PA, 579 NW Lake Whitney Place, Suite 105, Port St. Lucie, FL 34986, USA.
出版信息
Urol Case Rep. 2015 Jan 16;3(2):15-7. doi: 10.1016/j.eucr.2014.12.009. eCollection 2015 Mar.
The diagnosis of a testicular sclerosing Sertoli cell tumor is rare. Approximately 17 cases have been previously described in the literature worldwide. We present a case and review the evaluation and surgical management of a sclerosing Sertoli cell tumor presenting in a 26 year-old African-American adult, in association with testicular microlithiasis and oligospermia. Imaging techniques and the pathological assessment will be reviewed.
睾丸硬化性支持细胞瘤的诊断较为罕见。此前全球文献中大约已报道过17例。我们报告1例病例,并回顾1例26岁非裔美国成年男性患者的硬化性支持细胞瘤的评估及外科治疗情况,该病例伴有睾丸微结石症和少精子症。我们还将回顾影像技术及病理评估情况。